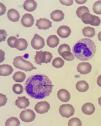

A 44-year-old male patient, healthy and without comorbidities, was diagnosed with COVID-19, dying 2 days after the observation of blue-green crystals inside neutrophils and monocytes in peripheral blood. Such crystals are described as amorphous blue-green inclusions, refringent and shiny, when stained by Romanowsky. They are generally related to severe tissue injury, such as that seen in liver failure and sepsis and, more recently, have been associated with COVID-191. They are also known as “crystals of death”, since most patients (65%) progress quickly to death after their microscopic finding (92% within 72h). Such inclusions have a high lipid content, which in association with their color and acidic nature, leads us to believe they are deposits of lipofuscin, which represents products of lysosomal degradation of necrotic liver cells that are phagocytized by neutrophils and monocytes (Figures 1 and 2).1–3
Conflicts of interestThe authors declare no conflicts of interest.